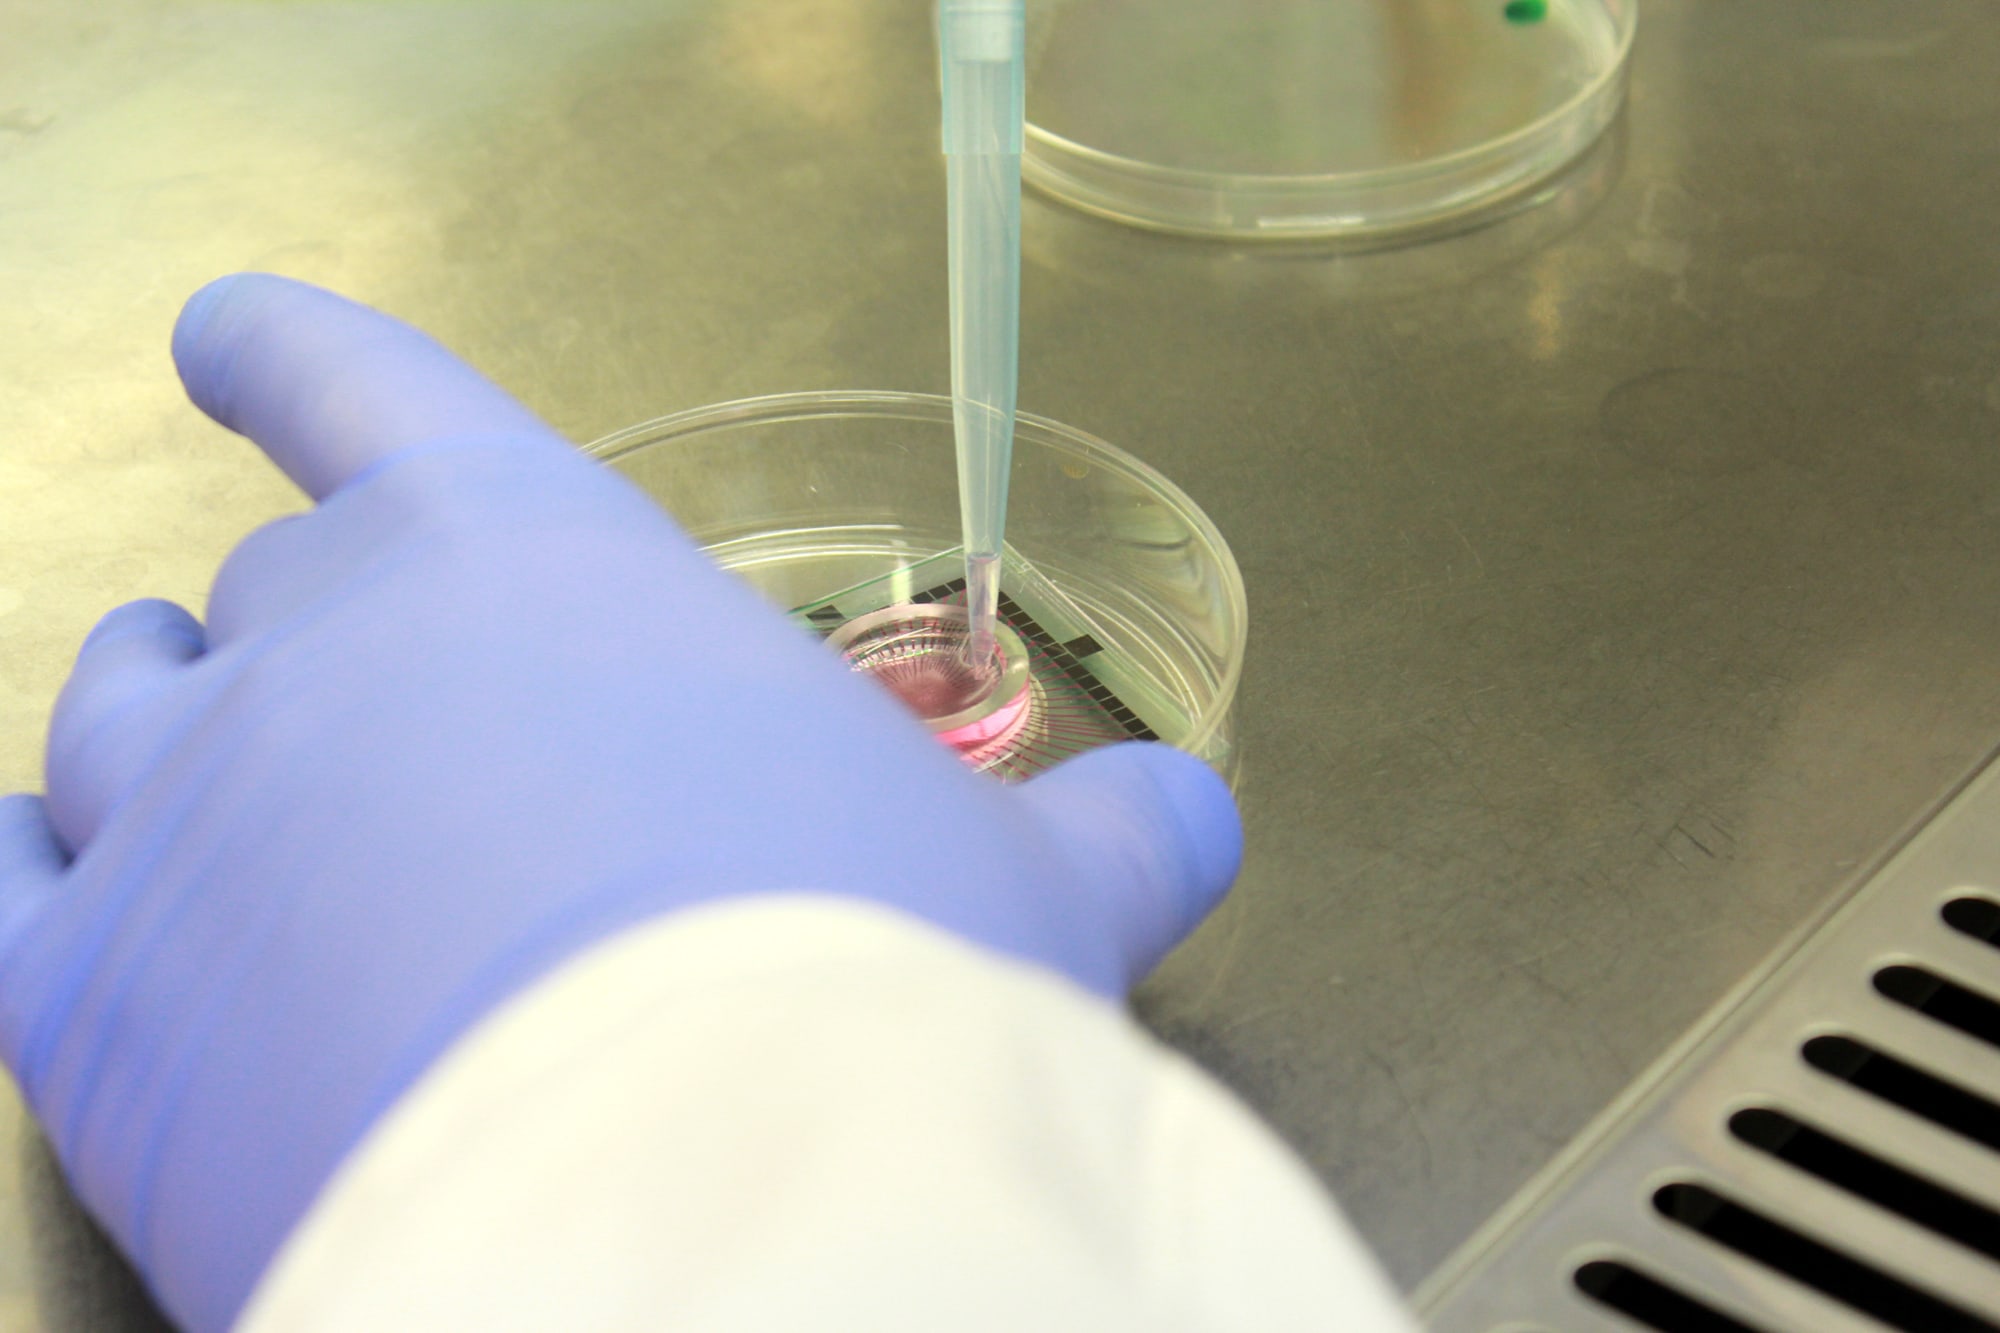

Guy Ben-Ary
Artist Talk

Photo courtesy Guy Ben-Ary
Artist Talk with Guy Ben-Ary
Guy Ben-Ary is an artist and a researcher at SymbioticA (University of Western Australia, Perth) an artistic laboratory dedicated to the research, learning and hands-on engagement with the life sciences. Recognised internationally as a major artist and innovator working across science and media arts, Guy specialises in biotechnological artwork, which aims to enrich our understanding of what it means to be alive. Guy’s work focuses on tissue engineering, microscopy and biological imaging. His research explores a number of fundamental themes that underpin the intersection of art and science; namely life and death, cybernetics, and artificial life. Much of Ben-Ary’s work is inspired by science and nature. His artworks utilise motion and growth and biological data to investigate technological aspects of today’s culture and the re-use of biological materials and technologies.
In his talk Guy Ben-Ary will present some of the methodologies and theories that underpin his artistic practice by using as examples, four of his major projects completed over the last decade: MEART, The Silent Barrage, In-Potentia, and CellF (see below). He will discuss issues related to terminology, ethics and robotic embodiment as an artistic strategy and his artistic attempt to match bio-engineered neural networks to artistic, robotic bodies.
CellF, a neural synthesizer, will perform with Schneider TM (12 May) and Stine Janvin (13 May) as part of Technosphärenklänge #3 at HKW
12-13 May, 2017